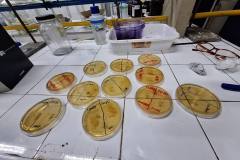

No dia 27 de setembro de 2023, a turma 2101 da ETE Oscar Tenório teve uma experiência enriquecedora durante uma visita técnica à UERJ. O principal objetivo da visita foi proporcionar aos estudantes o contato direto com ambientes acadêmico-científicos, visando a construção da identidade científica, especialmente para aqueles pertencentes a grupos subrepresentados nas ciências como mulheres, pessoas negras e com deficiência.
Durante a visita, os alunos tiveram a oportunidade de vivenciar as diferentes etapas da produção do conhecimento científico de maneira prática. O foco foi aprofundar os conhecimentos em áreas específicas, como Biologia Celular, Microscopia, Microbiologia e Astronomia.
Essa iniciativa não apenas buscou expandir o conhecimento acadêmico dos estudantes, mas também promoveu a inclusão e a diversidade, incentivando a participação ativa de grupos historicamente subrepresentados nas ciências. A visita técnica à UERJ foi uma experiência valiosa, contribuindo para o desenvolvimento acadêmico e científico dos alunos da turma 2101 da ETE Oscar Tenório.
Outras notícias
- ETEOT recebe representantes da FAETEC e da equipe do Projeto Vida para acompanhamento das ações desenvolvidas na escola
- FLOT 2026: Feira Literária Oscar Tenório terá como tema “Vozes, Memórias e Identidades”
- Programa +Estágio ETEOT: Curso Técnico em Gerência em Saúde
- Programa +Estágio ETEOT: Construindo seu futuro profissional desde agora
- Programa +Estágio ETEOT: Oportunidades, desafios e planejamento de carreira
- Programa +Estágio ETEOT: fortalecendo a conexão entre formação e mercado de trabalho
- Feira de Estágio NUBE 2026 e oportunidades da DIVEST
- Alunas da ETEOT conquistam prêmio de Iniciação Científica em congresso internacional
- Administração financeira em foco: Semana Financeira reúne especialistas e instituições parceiras
- Conselho de Classe reforça compromisso com a melhoria contínua do ensino na ETEOT
- Inscrições abertas para o Processo Seletivo FAETEC 2026.2
- Projeto VIDA: alunos participam do primeiro contato com os jogos
- Convite: Festival de Cinema da Era Atômica 2026
- SISPATRI 2026
- 1ª fase da OBMEP 2026